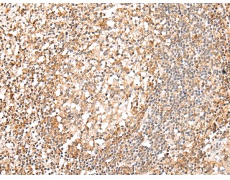
一抗

抗 原: HTR1B
反應(yīng)種屬: Human
技術(shù)規(guī)格
|
Background: |
The neurotransmitter serotonin (5-hydroxytryptamine; 5-HT) exerts a wide variety of physiologic functions through a multiplicity of receptors and may be involved in human neuropsychiatric disorders such as anxiety, depression, or migraine. These receptors consist of several main groups subdivided into several distinct subtypes on the basis of their pharmacologic characteristics, coupling to intracellular second messengers, and distribution within the nervous system (Zifa and Fillion, 1992 [PubMed 1359584]). The serotonergic receptors belong to the multigene family of receptors coupled to guanine nucleotide-binding proteins. |
|
Applications: |
ELISA, IHC |
|
Name of antibody: |
HTR1B |
|
Immunogen: |
Synthetic peptide of human HTR1B |
|
Full name: |
5-hydroxytryptamine (serotonin) receptor 1B, G protein-coupled |
|
Synonyms: |
S12; 5-HT1B; HTR1D2; HTR1DB; 5-HT1DB |
|
SwissProt: |
P28222 |
|
ELISA Recommended dilution: |
2000-5000 |
|
IHC positive control: |
Human tonsil |
|
IHC Recommend dilution: |
25-100 |


 購物車
購物車 幫助
幫助
 021-54845833/15800441009
021-54845833/15800441009